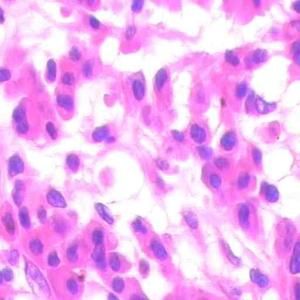
castleman病

簡介
Castleman病(Castleman’s disease,CD)屬原因未明的反應性淋巴結病之一,臨床較為少見。其病理特徵為明顯的淋巴濾泡、血管及漿細胞呈不同程度的增生,臨床上以深部或淺表淋巴結顯著腫大為特點部分病例可伴全身症狀和(或)多系統損害,多數病例手術切除腫大的淋巴結後,效果良好。
19世紀20年代CD首先被描述,1954年Castleman等正式報導一種局限於縱隔的腫瘤樣腫塊,組織學顯示淋巴濾泡及毛細血管明顯增生的疾病稱為 血管濾泡性淋巴結增生(vascular follicular lymphnode hyperplasia)。1969年Flendring和Schillings提出CD的另一形態學亞型,以漿細胞增生為特徵,常伴全身症狀。由於本病淋巴結腫大常十分明顯,有時直徑達10cm以上故又名 巨大淋巴結增生(giant lymphnode hyperplasia)。
病因
CD的病因未明。漿細胞型則認為可能和感染及炎症有關,有作者提出免疫調節異常是CD的始發因素,臨床上25%的中心型病例證實伴HHV-8感染,還認為至少部分CD處於B細胞惡性增生的危險中,少數多中心型可轉化為惡性淋巴瘤。然多數病例追隨結果並未轉化為惡性腫瘤。
病理學
腫大的淋巴結活檢顯示上述CD的特殊病理改變。病變主要累及身體任何部位的淋巴組織,偶可波及結外組織CD病理上分為以下兩種類型:
透明血管型:占80%~90%。淋巴結直徑為3~7cm,大者可達25cm,重量達700g。顯微鏡見淋巴結內許多增大的淋巴濾泡樣結構,呈散在分布。有數根小血管穿入濾泡,血管內皮明顯腫脹,管壁增厚,後期呈玻璃樣改變。血管周圍有數量不一的嗜酸性或透明狀物質分布。濾泡周圍由多層環心排列的淋巴細胞,形成特殊的洋蔥皮樣結構或帽狀帶濾泡間有較多管壁增厚的毛細血管及淋巴細胞、漿細胞、免疫母細胞,淋巴竇消失,或呈纖維化。有些病例增生的淋巴濾泡主要由小淋巴細胞組成,只有少數濾泡內有小生髮中心,稱為淋巴細胞型。這種類型最容易與濾泡性淋巴瘤混淆。
漿細胞型:占10%~20%。患者常伴有全身症狀,如發熱、乏力、體重減輕、貧血、紅細胞沉降率升高、血液丙種球蛋白增高和低白蛋白血症。淋巴結切除後症狀可消失。顯微鏡也可見見淋巴結內也顯示濾泡性增生但小血管穿入及濾泡周圍的淋巴細胞增生遠不及透明血管型明顯,一般無典型的洋蔥皮樣結構。本型的主要特徵為濾泡間各級漿細胞成片增生,可見Russell小體,同時仍有少量淋巴細胞及免疫母細胞。有人稱本型為透明血管型的活動期,可有TCRβ或IgH基因重排。有報導少數漿細胞型患者可並發卡波西肉瘤,以愛滋病伴發CD者多見。
少數患者病變累及多部位淋巴結,並伴結外多器官侵犯,病理上同時有上述兩型的特點稱為混合型。也有少數單一病灶者病理上兼有上述二型的特點,則為另一意義上的混合型。
發病機制
由於其淋巴結濾泡中存在一個以上的血管生髮中心,部分病例還有血管脂肪瘤成分,且病變也可發生於正常時不存在淋巴組織的部位,故曾認為是一種錯構瘤,血管造影的圖像也類似於其他的血管錯構瘤。以漿細胞增生為主的CD被認為和感染(主要是病毒感染)、炎症有關,因其病理上呈炎症樣改變,如漿細胞免疫母細胞及毛細血管增生同時均保留殘存的淋巴結結構;臨床上有炎症病變的徵象,如慢性病性貧血血沉增快、低白蛋白血症及多克隆免疫球蛋白增多等。有作者提出免疫調節異常是CD的始發因素,如典型的免疫缺陷疾患——愛滋病,可同時發生CD和卡波西(Kaposi)肉瘤少數CD也可轉化為卡波西肉瘤;臨床上部分患者伴自身免疫性血細胞減少、抗核抗體陽性類風濕因子陽性或抗人球蛋白試驗陽性;某些免疫學檢測顯示部分CD患者對抗原反應性消失、T抑制細胞缺如等有作者認為CD是一種腫瘤前期病變,因為CD病變組織的漿細胞免疫組化染色呈單克隆性、個別患者血中出現單株免疫球蛋白、少數多中心型患者可轉化為惡性淋巴瘤。
已有較多報導IL-6參與CD的發病過程,如IL-6基因轉入小鼠的造血幹細胞,可成功獲得類似於CD的病理模型。另已證實CD的淋巴結生髮中心的B淋巴細胞可分泌產生大量的IL-6。病變切除後,隨臨床病情的改善,增高的血清IL-6水平也隨之下降。此外,在動物實驗中證實,人皰疹病毒8(HHV-8),即卡波西肉瘤皰疹病毒(KSHV)參與了CD的發病。
症狀
CD臨床上分為局灶型及多中心型。
1.局灶型 青年人多見,發病的中位年齡為20歲。90%病理上為透明血管型。患者呈單個淋巴結無痛性腫大,生長緩慢形成巨大腫塊直逕自數厘米至20cm左右可發生於任何部位的淋巴組織,但以縱隔淋巴結最為多見,其次為頸、腋及腹部淋巴結偶見於結外組織如喉、外陰、心包、顱內皮下肌肉、肺、眼眶等均有個例報導。大部分無全身症狀,腫塊切除後可長期存活,即呈良性病程。10%病理為漿細胞型,腹腔淋巴結受累多見,常伴全身症狀如長期低熱或高熱乏力、消瘦貧血等,手術切除後症狀可全部消退,且不復發。
2.多中心型 較局灶型少見,發病年齡靠後,中位年齡為57歲。患者有多部位淋巴結腫大易波及淺表淋巴結。伴全身症狀(如發熱)及肝脾腫大,常有多系統受累的表現如腎病綜合徵、澱粉樣變、重症肌無力、周圍神經病變,顳動脈炎、舍格倫綜合徵(乾燥綜合徵)、血栓性血小板減少性紫癜及口腔、角膜炎性反應20%~30%的患者在病程中可並發卡波西肉瘤或B細胞淋巴瘤。少數患者若同時出現多發性神經病變、器官腫大(肝、脾)、內分泌病變、血清單株免疫球蛋白和皮膚病變,則構成POEMS綜合徵的臨床徵象。此外,多中心型臨床常呈侵襲性病程,易伴發感染。
併發症:
1.約1/3的患者可並發卡波西肉瘤或B細胞淋巴瘤。
2.合併神經系統、內分泌及腎臟病變,還可合併舍格倫綜合徵(乾燥綜合徵),血栓性血小板減少性紫癜等。
檢查
實驗室檢查
1.外周血 輕至中度正細胞正色素性貧血,部分病例有白細胞和(或)血小板減少也可表現為典型火罐網的慢性病性貧血。
2.骨髓象 部分患者漿細胞升高自2%~20%不等,形態基本正常。
3.血液生化及免疫學檢查 肝功能可異常,表現為血清轉氨酶及膽紅素水平升高少數病人腎功受累血清肌酐水平上升血清免疫球蛋白呈多克隆升高,較為常見,少數血清出現M蛋白,血沉也相應增快。部分患者抗核抗體類風濕因子及抗人球蛋白試驗陽性。
4.尿常規 尿蛋白輕度升高,如伴發腎病綜合徵,則出現大量蛋白。
其它檢查:
根據臨床表現、症狀、體徵選擇病理檢查、X線、CT、B超及心電圖等檢查。
相關檢查:
> Coombs試驗
> 單克隆丙種球蛋白
> 抗核抗體
> 漿細胞
> 類風濕因子
> 肌氨酸酐
> 蛋白定量(尿)
> 血小板
> 血沉
輔助檢查
1.組織病理學 腫大的淋巴結活檢顯示上述CD的特殊病理改變。病變主要累及身體任何部位的淋巴組織,偶可波及結外組織CD病理上分為以下兩種類型:
(1)透明血管型:占80%~90%淋巴結內顯示許多增大的淋巴濾泡樣結構,呈散在分布。有數根小血管穿入濾泡,血管內皮明顯腫脹,管壁增厚,後期呈玻璃樣改變。血管周圍有數量不一的嗜酸性或透明狀物質分布。濾泡周圍由多層環心排列的淋巴細胞,形成特殊的洋蔥皮樣結構或帽狀帶濾泡間有較多管壁增厚的毛細血管及淋巴細胞、漿細胞、免疫母細胞,淋巴竇消失,或呈纖維化。大體標本見淋巴結直徑為3~7cm,大者可達25cm,重量達700g
(2)漿細胞型:占10%~20%。淋巴結內也顯示濾泡性增生但小血管穿入及濾泡周圍的淋巴細胞增生遠不及透明血管型明顯,一般無典型的洋蔥皮樣結構。本型的主要特徵為濾泡間各級漿細胞成片增生,可見Russell小體,同時仍有少量淋巴細胞及免疫母細胞。有人稱本型為透明血管型的活動期,可有TCRβ或IgH基因重排。少數患者病變累及多部位淋巴結,並伴結外多器官侵犯,病理上同時有上述兩型的特點稱為混合型。也有少數單一病灶者病理上兼有上述二型的特點,則為另一意義上的混合型。有報導少數漿細胞型患者可並發卡波西肉瘤,以愛滋病伴發CD者多見。
2.根據臨床表現、症狀、體徵選擇X線、CT、B超及心電圖等檢查。
診斷
CD的臨床表現無特異性,凡淋巴結明顯腫大,伴或不伴全身症狀者,應想到CD的可能,淋巴結活檢獲上述典型的CD病理改變才能診斷,即CD的確診必須有病理學論據,然後根據臨床表現及病理,做出分型診斷。確診前還需排除各種可能的相關疾病。
鑑別診斷:
CD應和惡性淋巴瘤、各種淋巴結反應性增生(大多為病毒感染所致)、漿細胞瘤、愛滋病及風濕性疾病等鑑別。它們有某些相似的臨床表現和(或)病理改變,仔細的病理學檢查,包括免疫組化檢查,以及某些原發病的檢出是鑑別要點。本病的淋巴結腫大須與下列疾病鑑別:
1.淋巴瘤 雖然兩者都有淋巴結腫大但表現各有不同,淋巴瘤可有持續或周期發熱,全身瘙癢,脾大,消瘦等表現。而本病臨床症狀輕微,僅有乏力或臟器受壓後產生的症狀,最主要的是病理上的不同,本病組織學特點是顯著的血管增生。
2.血管免疫母細胞淋巴結病 是一種異常的非腫瘤性免疫增殖性疾病。臨床上多見於女性表現為發熱,全身淋巴結腫大可有皮疹及皮膚瘙癢輔助檢查白細胞增高,血沉增快,抗生素治療無效,激素可改善症狀。淋巴結病理表現為淋巴結破壞,毛細血管壁增生為免疫母細胞。血管內皮細胞間PAS陽性,無定形物質沉積,細胞間有嗜伊紅無結構物質沉積。活檢可鑑別。
3.原發性巨球蛋白血症 該病主要為淋巴樣漿細胞增生分泌大量單克隆巨球蛋白,並廣泛浸潤骨髓及髓外臟器。血清中出現大量單株IgM,無骨骼破壞無腎損害,臨床上有肝、脾淋巴結腫大,約半數伴高黏滯血症。
4.多發性骨髓瘤 是漿細胞疾病的常見類型骨髓內增生的漿細胞(或稱骨髓瘤細胞)浸潤骨骼和軟組織引起一系列器官功能障礙,臨床表現為骨痛、貧血、腎功能損害及免疫功能異常、高鈣血症。骨髓瘤細胞多浸潤肝脾、淋巴結及腎臟。CD淋巴結腫大明顯,淋巴結活檢可鑑別。
治療
局灶型CD均應手術切除,絕大多數患者可長期存活,復發者少。病理上為漿細胞型的局灶性CD,如伴發全身症狀,在病變的淋巴結切除後也可迅速消失。
多中心型CD,如病變僅侵及少數幾個部位者,也可手術切除,術後加用化療或放療病變廣泛的多中心型CD只能選擇化療,或主要病變部位再加局部放療,大多僅能獲部分緩解。化療通常選用治療惡性淋巴瘤的聯合化療方案。自體造血幹細胞移植也是一種治療選擇。
預後
本病為局灶性病變,預後較好,而多中心性並伴單克隆高丙球蛋白血症時,預後較差,易發性惡變轉化或淋巴瘤等。